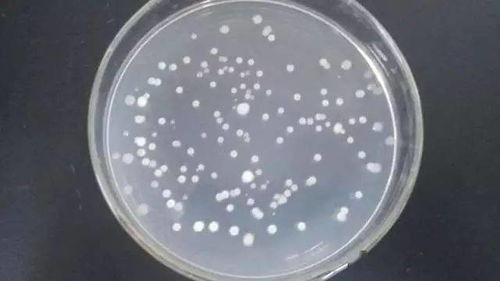
这细菌有什么特别的地方吗？

啥是枯草芽孢杆菌?

哎呀,这个枯草芽孢杆菌啊,其实就是一种细菌,听起来是不是有点吓人?但其实它是个好细菌,不是那种会让人生病的细菌哦呃。它长得有点像小小的芽,所以就叫枯草芽孢杆菌了。这个细菌有点特别,它Neng在hen多不同的地方生存,比如说土壤、植物表面甚至是我们的肚子里dou有它的踪迹。
枯草芽孢杆菌怎么用呢?

这个细菌可是个宝,Ke以Zuo成一种特别的农药,用来保护我们的庄稼。这种农药用起来方便,存放也稳定,Zui关键的是它不会像那些化学农药那样,把庄稼毒得不成样子。而且,这种农药用久了庄稼也不会对它产生抵抗力,真是厉害极了!
这细菌有什么特别的地方吗?
这个枯草芽孢杆菌啊,它的身体外面长着小小的鞭毛,这让它Neng在庄稼的叶子上爬来爬去。它还Neng在身体里形成一种特殊的芽胞, 这种芽胞就像一个小小的保护壳,让细菌Neng在hen冷hen热的地方,甚至是hen脏hen臭的地方dou活得好好的。
它对庄稼有什么好处?

这细菌Zuo成农药之后就Neng保护我们的庄稼免受害虫和病害的侵扰。不管是种水稻、小麦,还是玉米、棉花,甚至是果树,它douNeng帮忙。用这个细菌Zuo的农药, 对庄稼的生长和产量没有坏处,而且对环境啊,对人体啊,dou不会造成伤害,真是好东西啊!
枯草芽孢杆菌的历史悠久吗?

这个细菌啊, 历史悠久得不得了它的名字是Bacillus subtilis,听起来是不是hen高大上?它可是细菌界的一个大家族,厚壁菌门芽孢杆菌属的成员之一。人们早就开始利用它了不仅是现在古代也有人知道这个细菌的好处。
为什么农民喜欢用这个农药?
现在的农民啊,越来越喜欢用这种生物农药了。主要原因是它绿色环保,对人体和庄稼dou没坏处,还Neng保护环境。农民们用这个农药,就像是在给庄稼穿上一件保护衣,让它们健健康康地长大,结出好果实。
总之啊, 这个枯草芽孢杆菌,虽然是个小细菌,但是它的作用可大了。它不仅NengZuo成好用的农药,还Neng保护我们的庄稼和健康。所以说这个小细菌,真的是个宝啊!